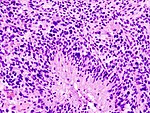
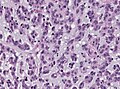
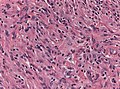
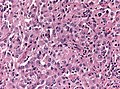

Neuropathology tumours

The article covers tumours in neuropathology. Tumours are a large part of neuropathology. Cytopathology of CNS tumours is dealt with in the article CNS cytopathology.
There are separate articles for peripheral nerve sheath tumours and pituitary/peri-pituitary lesions.
Brain tumours - overview
Alphabetical
For overview see here
By age group
Adult
Four most common types of brain tumours:[1]
- Metastatic brain tumours (barely edges out primary tumours)
- Lung (most common).
- Breast.
- Melanoma.
- Renal cell carcinoma (RCC).
- Glioblastoma, IDH-wildtype.
- Astrocytoma, IDH-mutant.
- Meningioma.
Children
- Pilocytic astrocytoma.
- Medulloblastoma.
- Ependymoma.
- Pontine glioma, often Diffuse midline glioma, H3 K27-altered.
By location
Certain tumours like to hang-out at certain places:[2]
Cerebrum
- Cortical based - oligodendroglioma.
- Grey-white junction - metastases.
- White matter - astrocytoma, glioblastoma.
- Periventricular - CNS lymphoma.
- Cystic - ganglioglioma, pilocytic astrocytoma, pleomorphic xanthoastrocytoma.
Cerebellum
- Midline/central - medulloblastoma.
- Cystic lesion - pilocytic astrocytoma (younger individual), hemangioblastoma (older individual).
- Solid lesion (older individual) - metastasis.
Sella turcica
less common:
- Pituicytoma.
- Granular cell tumour.
- Germinoma.
- Chordoma
- Rathke cleft cyst.
- Hypophysitis.
- Xanthogranuloma.
Spinal cord
- Ependymoma
- Glioblastoma
- Meningioma
- Carcinoma metastasis
- Hemangioblastoma
Filum terminale
Meninges
- Meningioma.
- Solitary fibrous tumour / Hemangiopericytoma.
- Hemangioblastoma.
less common:
- Melanoma / Melanocytoma.
- Lymphoproliferative diseases.
- Sarcoidosis
- Arachnoid cyst.
- Disseminated oligodendroglial-like leptomeningeal tumour.
- Desmoplastic infantile astrocytoma / ganglioglioma.
- Meningioangiomatosis.
- Calcifying pseudoneoplasm.
Skull
- Fibrous dysplasia.
- Paget disease.
- Histiocytosis.
- Hemangioma.
- Aneurysmal bone cyst.
- Multiple myeloma.
Skull base / Cerebellopontine angle
- Schwannoma.
- Meningioma.
- Dermoid cyst / epidermoid cyst.
less common:
- Ependymoma.
- Choroid plexus papilloma.
- Glomus tumour.
- Chordoma.
- Chondrosarcoma.
- Olfactory neuroblastoma.
- Endolymphatic sac tumour.
Primary versus secondary
- AKA (primary) brain tumour versus metastatic cancer.
Primary
- Cytoplasmic processes - key feature.
- Best seen at highest magnification - usu. ~1 micrometer.
- Processes may branch.
- Ill-defined border/blend with the surrounding brain.
- Lesion often dura-based.
- Mesenchymal tumor (often contains collagen).
- Primary CNS Lymphoma (PCNSL) is usu. a diffuse large B-cell lymphoma.
- Large (lymphoid) cells, ergo usu. not a difficult diagnosis.
- ~2x size of resting lymphocyte, nucleoli.
- Lesion predominantly perivascular.
Secondary
- Carcinomas:
- Well-demarcated border between brain and lesion - key feature.
- No cytoplasmic processes.
- Usu. have nuclear atypia of malignancy.
- Nuclei often ~3-4x the size of a RBC.
- +/-Glandular arrangement.
- +/-Nucleoli.
- Melanoma.
- Secondary Lymphoma.
- Sarcomas (rare).
By growth pattern
Infiltrative astrocytomas
- Astrocytoma, IDH-mutant.
- Glioblastoma, IDH-wildtype.
Notes:
- Glial: "blends into brain"/gradual transition to non-tumour brain.
Non-infiltrative astrocytomas
Cystic tumours
DDx:[3]
- Pilocytic astrocytoma.
- Pleomorphic xanthoastrocytoma.
- Ganglioglioma.
- Hemangioblastoma.
- Craniopharyngioma.[4]
Notes:
- Non-glial: no radiating glial processes.
- Rosenthal fibres within the tumour... often seen in pilocytic astrocytoma.
- Rosenthal fibres may be seen around a (very) slow growing tumour and represent a reactive process.
- Inflammatory cells and macrophages should prompt consideration of an alternate diagnosis (e.g. cerebral infarct, multiple sclerosis) - esp. if this is a primary lesion.[5]
Grading
Nuclear pleomorphism present:
- At least grade II (diffuse astrocytoma).
Mitotic figures present:
- At least grade III (anaplastic astrocytoma).
Microvascular proliferation or necrosis with pseudopalisading tumour cells:
- Grade IV (glioblastoma AKA glioblastoma multiforme).
Notes:
- Pseudopalisading tumour cells = high tumour cell density adjacent to regions of necrosis; palisade = a fence of poles forming a defensive barrier or fortification.
- WHO Grading is currently based on expected biologiocal behaviour without treatment.
- Grading does not reflect molecular divergent groups within a tumor class or response to therapy (Currently controversies in grading for IDH-mutant astrocytoma vs. IDH-wildtype astrocytoma).[6]
By IHC
- GFAP - should stain cytoplasm of tumour cells and the perikaryon (nuclear membrane) of most Astrocytomas.
- IDH-1(R132H) (isocitrate dehydrogenase 1) in Astrocytoma, IDH-mutant.[7][8]
- H3F3A K27M in Diffuse midline glioma, H3 K27-altered.
- ATRX -ve in Astrocytoma, IDH-mutant or Diffuse hemispheric glioma, H3 G34-mutant.
- CD20 in PCNSL.
- Cytokeratins in Carcinoma brain metastases, Plexus choroid tumours, AT/RT, Papillary tumour of the pineal region, Craniopharyngioma.
- EMA in Meningioma and carcinoma brain metastases.
- PrgR in Meningioma and carcinoma metastases.
- Synaptophysin in glioneuronal tumours and Pituitary adenoma and embryonal tumours.
Common neuropathology tumours in a table
| Type | Key feature(s) | Imaging | History | Notes | IHC | Images |
| Normal tissue | cells regularly spaced, no nuc. atypia | small lesion? / deep lesion? | variable | missed lesion? | nil | |
| Reactive astrocytes | astrocytes with well-demarcated eosinophilic cytoplasm, regular spacing, no nuc. atypia | small lesion? / deep lesion? | variable | missed lesion / close to a lesion; non-specific pathologic process - need more tissue | GFAP | |
| Schwannoma | cellular areas (Antoni A), paucicelluar areas (Antoni B), palisading of nuclei (Verocay bodies) | extra-axial + intradural | old or young | need frozen section to Dx, DDx: meningioma | S100, SOX10 | |
| Meningioma | whorls, psammomatous calcs, nuclear inclusions | extra-axial + intradural | old or young | may be diagnosed on smear, DDx: schwannoma, choroid plexus | EMA, PR, Ki-67 | |
| Astrocytoma, IDH-mutant (CNS WHO grade 2 or grade 3) | glial processes (esp. on smear), nuclear atypia (typical size var. ~3x, irreg. nuc. membrane, hyperchromasia), no Rosenthal fibres in the core of the lesion †, no microvascular proliferation, no necrosis | often enhancing (suggests high grade), usu. supratentorial, usu. white matter | usu. old, occ. young | common | IDH-1(R132H)+/-, GFAP+ | |
| Glioblastoma, IDH-wildtype (CNS WHO grade 4) | glial processes (esp. on smear), nuclear atypia (typical size var. ~3x, irreg. nuc. membrane, hyperchromasia), no Rosenthal fibres in the core of the lesion †, microvascular proliferation or necrosis | often enhancing (suggests high grade), usu. supratentorial, usu. white matter | usu. old, occ. young | very common, esp. glioblastoma | IDH-1+/-, GFAP+ | |
| Metastasis | sharp interface with brain, often glandular, +/-nucleoli, no glial processes | often cerebellular, well-circumscribed | usu. old | often suspected to have metastatic disease | TTF-1, CK7, CK20, BRST-2 |
† Rosenthal fibres at the periphery of a lesion are a non-specific finding seen in chronic processes.
Brain metastasis
Molecular
See also: Molecular Neuropathology
Gliomas
Gliomas, glioneuronal tumours and neuronal tumours are often categorized together.
Astrocytic tumours
- Astrocytoma, IDH-mutant.
- Glioblastoma, IDH-wildtype.
- Gliosarcoma (a glioblastoma subtype)
- Glial processes - key feature.
- Thin stringy cytoplasmic processes - best seen at high power in less cellular areas.
- No Rosenthal fibres within the tumour itself.
Images:
- Endothelial proliferation in a GBM (ouhsc.edu).
- Endothelial proliferation (ouhse.edu).
- Gemistocytic astrocytoma - several images (upmc.edu).
Depreceated:
- Diffuse Astrocytoma
- Anaplastic astrocytoma
- Gliomatosis cerebri
- Spongioblastoma
Oligodendroglial tumours
- Oligodendroglioma, IDH-mutant and 1p/19q codeleted.
Depreceated:
- Anaplastic oligodendroglioma
- Oligoastrocytoma
- Anaplastic oligoastrocytoma
Pediatric-type diffuse high-grade glioma
Pediatric-type diffuse low-grade glioma
Circumscribed astrocytic gliomas
- Pilocytic astrocytoma (PA)
- Pilomyxoid astrocytoma (PMA)
- Pleomorphic xanthoastrocytoma (PXA)
- Subependymal giant cell astrocytoma (SEGA)
- Astroblastoma MN1-altered.
- Chordoid glioma.
Astroblastoma
- No WHO grade yet.[11]
- Very rare superficial tumor of young age.[12]
- Large, cystic. Pushing margin towards CNS.
- Vasocentric growth, plump cells with absence of fibrillary pattern.
- GFAP+ve, Synaptohysin-ve, Olig-2-ve, focally EMA/panCK+ve. MIB-1: 1-18 %.
- Molecular profile overlaps with classical CNS-PNET.
- Gene fusions invoving meningioma gene (MN1)[13]
Chordoid glioma of the third ventricle
- WHO grade II.
- Slowly growing, non-invasive, in adults.
- Clusters of epithelioid cells in mucinous stroma.
- Lymphocytic infiltrates, adjacent Rosenthal fibers.
- Fibrosis may be present.
- Few mitoses.
- GFAP+ve, MIB-1 1-3%.
- TTF-1+ve.
- CD34+ve.
- IDH-1-ve, p53-ve.
- PRKCA D463H mutations.[14]
Ependymal tumours
- Subependymoma
- Myxopapillary Ependymoma
- Ependymoma
- Anaplastic ependymoma
Choroid plexus tumours
- Choroid plexus papilloma
- Atypical choroid plexus papilloma
- Choroid plexus carcinoma
Other neuroepithelial tumours
Cribiform neuroepithelial tumour
AKA: CRINET.
- Not listed in the current WHO classification.
- First description in 2009.[15]
- Around ventricles.[16]
- Young children.[17]
- Small undifferentiated cells arranged in cribriform strands and trabeculae of varying thickness.
- MAP2+ve, Synaptophysin+ve, CK+/-ve. MIB-1: 30%.
- INI-1 loss, but no rhabdoid features and good prognosis.
- Stable genomic profile.[18]
Neuronal and mixed neuronal/glial tumours
- Desmoplastic infantile astrocytoma / ganglioglioma (DIA/DIG)
- Dysembryoplastic neuroepithelial tumour
- Central Neurocytoma / Extraventricular neurocytoma
- Cerebellar liponeurocytoma
- Papillary glioneuronal tumour (PGNT)
- Rosette-forming glioneuronal tumour of the fourth ventricle (RGNT)
- Gangliocytoma / Ganglioglioma
- Dysplastic ganglioglioma of the cerebellum (Lhermitte-Duclos disease)
- Paraganglioma
Desmoplastic infantile astrocytoma / Desmoplastic infantile ganglioglioma
- Abbreviated DIA or DIG.
- ICD-O code: 9412/1
- Large, superficial, cystic tumor of the infancy.
- Biologic course corresponds to WHO grade I.
- Very rare, included in the WHO since 1993.
- Prominent desmoplastic stroma.
- Astrocytic cells within stroma.
- GFAP+.
- MIB-1 usu. 1%.
- Frequent BRAF V600E or V600D mutations.[19]
- Single case with BRAF indel or BRAF fusion.
Cerebellar liponeurocytoma
- Previously called lipomatous medulloblastoma (name changed in WHO 2000).
- Mean age: 50 years.
- As the name states: A tumour of the cerebellum.
- But cases outside cerebellum reported that would qualify.[20]
- WHO grade II [21] (upgraded from WHO grade I in 2007)[22]
- ICD-O code: 9506/1
Histo
- Advanced neuronal and lipomatous differentiation.
- Neurocytes: round to oval nuclei with clear cytoplasm.
- Quite cellular.
- Mitoses almost absent.
IHC
Molecular
- Distinct methylation profile.
- Recurent losses on 2p and Chr. 14.[23]
DDx
Gangliocytoma
- Grade I WHO neuronal tumour.
- ICD-O code: 9492/0
- Groups of irregular large neurons.
- Non-neoplastic, reticulin-rich glial stroma.
Ganglioglioma
- Not to be confused with ganglioneuroma.
General
- Gangliolioma: Grade I WHO mixed neuronal-glial tumour (ICD-O code: 9505/1).
- Anaplastic ganglioglioma: Grade III (ICD-O: 9505/3)
- Rare (approx. 0.5% of all CNS tumors).
- Usu. temporal lobe.
- Predominantly children (mean age: 9 years).
- Recognized as a cause of epilepsy.[24]
- Favourable prognosis (survival rates up to 97%)
- Insufficient data für anaplastic ganglioglioma.
Macroscopic
- Circumscribed lesion.
- Usu. contrast enhancing.
- Solid, but intracortical cysts may be present.
- Little mass effect.
Microscopic
Features:
- Dysplastic neurons.
- Out of regular architecture / abnormal location.
- Cytomegaly
- Clustering
- Binucleated (very occassionally).
- Atypical glia.
- Eosinophilic granular bodies.
- Calcification.
- Prominent capillary network.
- Lymphocytic cuffing.
- May contain some reticulin.
- Glial component may resemble:
- Fibrillary astrocytoma.
- Oligodendroglioma.
- Pilocytic astrocytoma.
Anaplastic ganglioglioma:
- Brisk mitotic activity
- Necrosis
IHC
- Neurons:
- MAP2 +ve
- Synaptophysin +ve
- Neurofilament +ve
- Glia:
- CD34+/-ve
- BRAF V600E +ve (approx. 25%, mainly ganglion cells).
Molecular
- BRAF V600E-mutated(approx. 25%).
- IDH1/2 wt.
- No 1p/19q codeletion.
- Usu. Chr. 7 gain.
- CDKN2A deletions in anaplastic ganglioglioma.
DDx:
- DNT.
- Oligodendroglioma.
- Trapped cortical neurons in diffuse astrocytoma.
- Papillary glioneuronal tumor.
- Dysembryoplastic neuroepithelial tumor.
Images
Lhermitte-Duclos disease
- Abbreviated LDD.
- AKA dysplastic cerebellar gangliocytoma.[25]
- AKA dysplastic gangliocytoma of the cerebellum.
Papillary glioneuronal tumour
- Abbreviated PGNT.
- A benign, supratentorial tumor of childhood.
- Biologic course corresponds to WHO grade I.
- Before WHO 2000, considered a Ganglioglioma variant.
- Prominent pseudopapillary architecture.
- Neurocytes to medium-sized ganglion cells.
- GFAP+ core, GFAP- layer
- Rosenthal fibers, Eosinophilic Granular bodies and lymphocytic cuffing may be present.
Rosette-forming glioneuronal tumour of the fourth ventricle
- Abbreviated RGNT.
- Provisional ICD-O code: 9509/1
- A rare benign infratentorial tumour of the midline of children and adults.
- Biologic course corresponds to WHO grade I.
- Glial component corresponds to pilocytic astrocytoma.
- Neurocytic rosettes.
- Eosinopil fibrillary cores / pseudorosettes.
- GFAP+ in fibrillary areas, Syn+ in rosettes.
- Neurocytic cells: MAP2+
- MIB-1 usu. below 3%.
Polymorphous low-grade tumor of the young (PLNTY)
Pineal tumours
- Pineocytoma
- Pineal parenchymal tumour of intermediate differentiation
- Pineoblastoma
- Papillary tumour of the pineal region
Embryonal tumours
- Atypical teratoid/rhabdoid tumour (AT/RT) or (AT-RT)
- Medulloblastoma
- Primitive neuroectodermal tumour (PNET)
- Embryonal tumour with abundant neuropil and true rosettes (ETANTR)
DDx:
Peripheral nerve sheath tumours
A classification:[26] Benign:
- Schwannoma.
- Neurofibroma.
- Perineurioma.
- Ganglioneuroma.
Malignant:
Ganglioneuroma
- Not to be confused with ganglioglioma.
Meningioma
Chordoma
Hemangioblastoma
CNS lymphoma
Classification:
- Primary CNS lymphoma.
- Non-primary CNS lymphoma - see lymphoma article.
General - primary CNS
- Classically periventicular distribution.
- Usually large B cell; can be considered a type of diffuse large B cell lymphoma (DLBCL).
- Prognosis of CNS (DLBCL) lymphomas worse than nodal (non-CNS) DLBCL.[28]
Microscopic
Features:
- Large cell lymphoma.
- Size = 2x diameter normal lymphocyte.
- Nucleolus - common.
- Perivascular clustering.
Images
www:
IHC
Can be subclassified in GCB (germinal centre B-cell-like) and non-GCB by CD10, Bcl-6, MUM1/IRF-4, and Bcl-2.[28]
Common pattern:
- CD20 +ve - key stain.
- CD3 -ve.
- Ki-67 ~40%.
- Bcl-6 +ve.
- Bcl-1 -ve.
Ganglioneuroblastoma
General
- Uncommon.
- Part of the neuroblastic tumours group which includes:[29]
- Ganglioneuroma (benign).
- Ganglioneuroblastoma (intermediate).
- Neuroblastoma (aggressive).
Microscopic
Features:
- Ganglion-like cells with a prominent nucleolus.
- Small undifferentiated cells with scant cytoplasm.
Images:
IHC
- NSE +ve -- small cells.
Lesions of the sella turcica
Lesions of the sella turcica, the pituitary gland environs, is a topic for it self. The differential diagnosis for lesions in this area includes:
- Pituitary adenoma.
- Craniopharyngioma.
- Rathke cleft cyst.
- Germ cell tumour.
- Meningioma.
- Pilomyxoid astrocytoma - in children.
See also
References
- ↑ http://neurosurgery.mgh.harvard.edu/abta/primer.htm
- ↑ URL: http://www.msdlatinamerica.com/ebooks/DiagnosticNeuropathologySmears/files/4ce563fb7e8e48fc9ed8b42e296a7747.gif and http://www.msdlatinamerica.com/ebooks/DiagnosticNeuropathologySmears/sid117213.html. Accessed on: 2 November 2010.
- ↑ URL: http://path.upmc.edu/cases/case320/dx.html. Accessed on: 14 January 2012.
- ↑ URL: http://www.pathologyoutlines.com/Cnstumor.html#cystsgeneral. Accessed on: 14 January 2012.
- ↑ URL: http://path.upmc.edu/cases/case79/dx.html. Accessed on: 2 January 2012.
- ↑ Louis, DN.; von Deimling, A. (Aug 2017). "Grading of diffuse astrocytic gliomas: Broders, Kernohan, Zülch, the WHO… and Shakespeare.". Acta Neuropathol. doi:10.1007/s00401-017-1765-z. PMID 28801693.
- ↑ Yan H, Parsons DW, Jin G, et al. (February 2009). "IDH1 and IDH2 mutations in gliomas". N. Engl. J. Med. 360 (8): 765–73. doi:10.1056/NEJMoa0808710. PMC 2820383. PMID 19228619. https://www.ncbi.nlm.nih.gov/pmc/articles/PMC2820383/.
- ↑ Houillier C, Wang X, Kaloshi G, et al. (October 2010). "IDH1 or IDH2 mutations predict longer survival and response to temozolomide in low-grade gliomas". Neurology 75 (17): 1560–6. doi:10.1212/WNL.0b013e3181f96282. PMID 20975057.
- ↑ Rong Y, Durden DL, Van Meir EG, Brat DJ (June 2006). "'Pseudopalisading' necrosis in glioblastoma: a familiar morphologic feature that links vascular pathology, hypoxia, and angiogenesis". J. Neuropathol. Exp. Neurol. 65 (6): 529–39. PMID 16783163.
- ↑ http://dictionary.reference.com/browse/palisading
- ↑ The International Agency for Research on Cancer (Editors: Louis, D.N.; Ohgaki, H.; Wiestler, O.D.; Cavenee, W.K.) (2007). Pathology and Genetics of Tumours of Tumors of the Central Nervous System (IARC WHO Classification of Tumours) (4th ed.). Lyon: World Health Organization. pp. 88. doi:10.1007/s00401-007-0243-4. ISBN 978-9283224303.
- ↑ Narayan, S.; Kapoor, A.; Singhal, MK.; Jakhar, SL.; Bagri, PK.; Rajput, PS.; Kumar, HS.. "Astroblastoma of cerebrum: A rare case report and review of literature.". J Cancer Res Ther 11 (3): 667. doi:10.4103/0973-1482.140800. PMID 26458709.
- ↑ Sturm, D.; Orr, BA.; Toprak, UH.; Hovestadt, V.; Jones, DT.; Capper, D.; Sill, M.; Buchhalter, I. et al. (Feb 2016). "New Brain Tumor Entities Emerge from Molecular Classification of CNS-PNETs.". Cell 164 (5): 1060-72. doi:10.1016/j.cell.2016.01.015. PMID 26919435.
- ↑ Goode, B.; Mondal, G.; Hyun, M.; Ruiz, DG.; Lin, YH.; Van Ziffle, J.; Joseph, NM.; Onodera, C. et al. (02 2018). "A recurrent kinase domain mutation in PRKCA defines chordoid glioma of the third ventricle.". Nat Commun 9 (1): 810. doi:10.1038/s41467-018-02826-8. PMID 29476136.
- ↑ Hasselblatt, M.; Oyen, F.; Gesk, S.; Kordes, U.; Wrede, B.; Bergmann, M.; Schmid, H.; Frühwald, MC. et al. (Dec 2009). "Cribriform neuroepithelial tumor (CRINET): a nonrhabdoid ventricular tumor with INI1 loss and relatively favorable prognosis.". J Neuropathol Exp Neurol 68 (12): 1249-55. doi:10.1097/NEN.0b013e3181c06a51. PMID 19915490.
- ↑ Arnold, MA.; Stallings-Archer, K.; Marlin, E.; Grondin, R.; Olshefski, R.; Biegel, JA.; Pierson, CR.. "Cribriform neuroepithelial tumor arising in the lateral ventricle.". Pediatr Dev Pathol 16 (4): 301-7. doi:10.2350/12-12-1287-CR.1. PMID 23495723.
- ↑ Park, JY.; Kim, E.; Kim, DW.; Chang, HW.; Kim, SP. (Oct 2012). "Cribriform neuroepithelial tumor in the third ventricle: a case report and literature review.". Neuropathology 32 (5): 570-6. doi:10.1111/j.1440-1789.2011.01293.x. PMID 22239490.
- ↑ Gessi, M.; Japp, AS.; Dreschmann, V.; Zur Mühlen, A.; Goschzik, T.; Dörner, E.; Pietsch, T. (Oct 2015). "High-Resolution Genomic Analysis of Cribriform Neuroepithelial Tumors of the Central Nervous System.". J Neuropathol Exp Neurol 74 (10): 970-4. doi:10.1097/NEN.0000000000000239. PMID 26352987.
- ↑ Wang, AC.; Jones, DTW.; Abecassis, IJ.; Cole, BL.; Leary, SES.; Lockwood, CM.; Chavez, L.; Capper, D. et al. (Jul 2018). "Desmoplastic Infantile Ganglioglioma/Astrocytoma (DIG/DIA) are Distinct Entities with Frequent BRAFV600 Mutations.". Mol Cancer Res. doi:10.1158/1541-7786.MCR-17-0507. PMID 30006355.
- ↑ Gupta, K.; Salunke, P.; Kalra, I.; Vasishta, RK.. "Central liponeurocytoma: case report and review of literature.". Clin Neuropathol 30 (2): 80-5. PMID 21329617.
- ↑ Nishimoto, T.; Kaya, B. (Aug 2012). "Cerebellar liponeurocytoma.". Arch Pathol Lab Med 136 (8): 965-9. doi:10.5858/arpa.2011-0337-RS. PMID 22849747.
- ↑ Brat, DJ.; Parisi, JE.; Kleinschmidt-DeMasters, BK.; Yachnis, AT.; Montine, TJ.; Boyer, PJ.; Powell, SZ.; Prayson, RA. et al. (Jun 2008). "Surgical neuropathology update: a review of changes introduced by the WHO classification of tumours of the central nervous system, 4th edition.". Arch Pathol Lab Med 132 (6): 993-1007. doi:10.1043/1543-2165(2008)132[993:SNUARO]2.0.CO;2. PMID 18517285.
- ↑ Capper, D.; Stichel, D.; Sahm, F.; Jones, DTW.; Schrimpf, D.; Sill, M.; Schmid, S.; Hovestadt, V. et al. (Jul 2018). "Practical implementation of DNA methylation and copy-number-based CNS tumor diagnostics: the Heidelberg experience.". Acta Neuropathol. doi:10.1007/s00401-018-1879-y. PMID 29967940.
- ↑ Im, SH.; Chung, CK.; Cho, BK.; Lee, SK. (Mar 2002). "Supratentorial ganglioglioma and epilepsy: postoperative seizure outcome.". J Neurooncol 57 (1): 59-66. PMID 12125968.
- ↑ Yağci-Küpeli, B.; Oguz, KK.; Bilen, MA.; Yalçin, B.; Akalan, N.; Büyükpamukçu, M. (Mar 2010). "An unusual cause of posterior fossa mass: Lhermitte-Duclos disease.". J Neurol Sci 290 (1-2): 138-41. doi:10.1016/j.jns.2009.12.010. PMID 20060133.
- ↑ Wippold FJ, Lubner M, Perrin RJ, Lämmle M, Perry A (October 2007). "Neuropathology for the neuroradiologist: Antoni A and Antoni B tissue patterns". AJNR Am J Neuroradiol 28 (9): 1633–8. doi:10.3174/ajnr.A0682. PMID 17893219. http://www.ajnr.org/cgi/reprint/28/9/1633.
- ↑ URL: http://medical-dictionary.thefreedictionary.com/ganglioma. Accessed on: 8 November 2010.
- ↑ 28.0 28.1 Raoux D, Duband S, Forest F, et al. (June 2010). "Primary central nervous system lymphoma: Immunohistochemical profile and prognostic significance". Neuropathology 30 (3): 232–40. doi:10.1111/j.1440-1789.2009.01074.x. PMID 19925562.
- ↑ Shimada H, Ambros IM, Dehner LP, Hata J, Joshi VV, Roald B (July 1999). "Terminology and morphologic criteria of neuroblastic tumors: recommendations by the International Neuroblastoma Pathology Committee". Cancer 86 (2): 349–63. PMID 10421272.